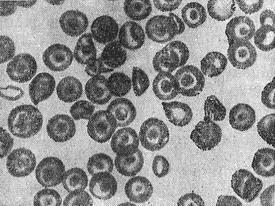

Таласемія (синонім: анемія Кулі, анемія мишеневидноклеточная) - спадкова гемолітична анемія у дітей. Захворювання розвивається у зв'язку з порушенням нормального синтезу гемоглобіну і збереженням синтезу фетального (ембріонального) гемоглобіну, освітою дегенеративних форм і прискореним руйнуванням еритроцитів.
В СРСР таласемія спостерігається в республіках Закавказзя і Середньої Азії.
Виділяють дві основні форми захворювання: велику талассемию - гомозиготный варіант, при якій клінічні ознаки найбільш виражені, і малу талассемию - гетерозиготний варіант (див. Спадковість).
Клінічно відзначається прогресуюча гіпохромна анемія, эритробластемия, збільшення печінки і селезінки, жовтянична забарвлення шкіри, остеопороз, деформація лицьового черепа, дитина фізично недорозвинений.
![]() Кров хворого, який страждає таласемією. Видно мишеневидные еритроцити. |
Діагноз встановлюється на підставі клінічних і гематологічних даних, а також при виявленні мишеневидных еритроцитів з центральним розташуванням гемоглобіну (рис.).
Лікування симптоматичне: показано переливання крові та еритроцитної маси, видалення селезінки. Ефект тимчасовий. Прогноз залежить від форми захворювання. Хворі доживають до зрілого віку тільки при малій таласемії, що протікає з менш вираженими клінічними проявами. См. також Анемія (у дітей), Гемолітична анемія, Спадкові хвороби.